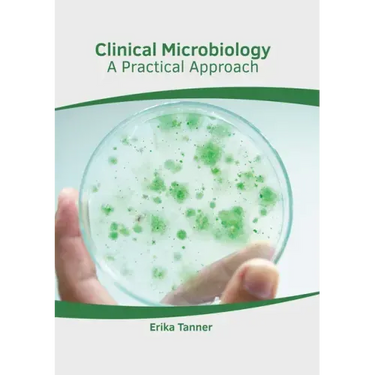

Clinical Microbiology: A Practical Approach - Hardcover
Clinical Microbiology: A Practical Approach - Hardcover
$167.99
/

products.product.pickup_availability.unavailable
Your payment information is processed securely. We do not store credit card details nor have access to your credit card information.
by Erika Tanner (Editor)
Clinical microbiology is the discipline of medical science that focuses on the prevention, diagnosis and treatment of infectious diseases. Numerous clinical applications of microbes for better health are studied in this domain. Clinical microbiology is also characterized as one of the largest sub-fields of microbiology that is applied to medicine. This field commonly focuses on the treatment of infection caused by various bacteria, fungus, viruses and parasites. The treatment of diseases caused by these pathogens is advised after studying their characteristics such as mechanisms of infection, growth and modes of transmission. The most important part of clinical microbiology is epidemiology, which studies the patterns, causes and effects of health and disease in people. The clinical aspect of the field aims to focus on the presence and growth of microbial infections in individuals, their effects on the human body, and the methods of treating these infections. This book unravels the recent studies in the field of clinical microbiology. It traces the progress of this field and highlights some of its key concepts and applications. This book is a resource guide for experts as well as students.